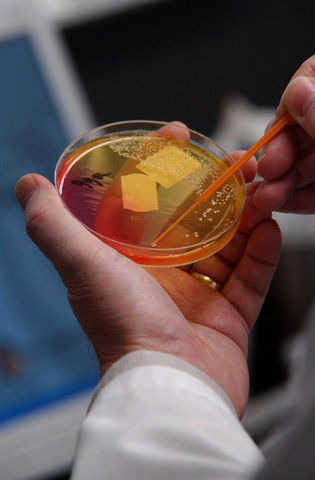
World standard of food safety.

-
On October 4, 1957, the Soviet Union put Sputnik, the world’s first satellite, into orbit.
-
-
Food was an integral part of putting a man into space; food that would not only provide concentrated nutrition, but would not create any health issues. Above all, the food had to be safe. An astronaut who became sick would be a danger to himself and the mission.
-
In 1959, Pillsbury joined the program as a contractor and began working on cube-sized foods for space flight. Producing foods that would not crumble in zero gravity and provide adequate nutrition was only one of the problems; food safety was another.
-
NASA & Pillsbury soon realized that traditional quality control methods would be inadequate to guarantee the food’s safety, as testing and analysis alone would not suffice. In fact, to ensure that the food was safe, manufacturers had to test so much product that there was little left for actual use.
-
The search for a better way came in part from NASA’s own requirements. NASA had mandated the use of critical control points (CCPs) in engineering management, so it was a logical step to apply this same process to food manufacturing. The CCP approach adopted by NASA apparently had first been practiced in the munitions industry as a means to ensure the reliability of shells.
-
Because of the large complex distribution system that we use to deliver our food from the supplier to the consumer, any situation that arises concerning the safety of the food product can result in literally hundreds of people becoming ill.
-
The success of HACCP in controlling hazards in food processing establishments led to consumer and regulator clamor to apply HACCP from “farm to table”. HACCP is now regulated nationally, and provincially the regulations state that HACCP is required.
-
• Improve your operation from the regulatory standpoint and provide for the safety of your food products.
• Reduce the chance for food-borne illness.
• Identify and document where corrections need to be made.
• Have you thoroughly review your operation specifically for food safety and place controls on those areas of concern. -
HACCP is a concept as well as a method of operation. When it comes to pathogens, sight, smell, and taste just do not get it done. We must have control over the process. Having a HACCP plan will:
*Improve your operation from the regulatory standpoint and provide for the safety of your food products.
*Reduce the chance for food-borne illness.
*Identify and document where corrections need to be made. -
The Hazard Analysis and Critical Control Points system (HACCP) was developed to focus specifically on food safety. A major focus of the new HACCP system is from farm to table. In short, everyone is responsible for safe food products.
-
Canadians have become increasingly concerned about food safety. Incidences of food-borne illness are receiving more attention as consumers have become more aware of new pathogens that threaten all of us. The Hazard Analysis and Critical Control Points system (HACCP) was developed to focus specifically on food safety. A major focus of the new HACCP system is from farm to table. In short, everyone is responsible for safe food products.
-
HACCP is a concept as well as a method of operation. When it comes to pathogens, sight, smell, and taste just do not get it done. We must have control over the process, the raw materials, the environment, and the people, beginning as early in the food production system as possible.
-
The ultimate responsibility for food safety at the retail level lies with retail and food service operators and their ability to develop and maintain effective food safety management systems. The goal is to provide you with a practical, HACCP-based approach.
-
Since its birth in 1960, the HACCP system has grown to become the world standard of food safety. The future may see the addition of more principles, perhaps related to training, validation, prerequisite programs, etc. established features of HACCP that have not changed.
-
More Canadians suffer food poisoning.
Up to 13 million Canadians, more than 40 per cent of the population will suffer from food-borne illnesses this year, an epidemic that medical experts say costs up to $1.3 billion annually in lost productivity and medical expenses. THE OTTAWA CITIZEN MAY 26, 2008 -
[HACCPCanada](haccpcanada.net) As HACCP is still the best available system for managing food safety, we at HACCP Canada felt it was our duty and obligation to honor its creation and development in this feature.
-
On this occasion of the 50th anniversary of HACCP, it is tempting to look forward and envision further improvements that can be accomplished. To a very large extent, global food corporations have implemented HACCP around the world without significant assistance (other than the Codex document described above) from governmental and intergovernmental food regulatory and health agencies.
-
[The initial HACCP system was based on seven principles:](haccpcanada.net)
- Conduct a hazard analysis.
- Determine the CCPs.
- Establish critical limit(s).
- Establish a system to monitor control of the CCPs.
- Establish the corrective action to be taken when monitoring indicates that a particular CCP is not under control.
- Establish procedures for verification to confirm that the HACCP system is working effectively.
- Establish documentation concerning all procedures and records appropriate to the
A list shows items. A timeline shows sequence.
Use Timetoast to make dates, milestones, and turning points easier to understand in a clear visual format. Timetoast is a timeline maker for work, school, research, and stories.